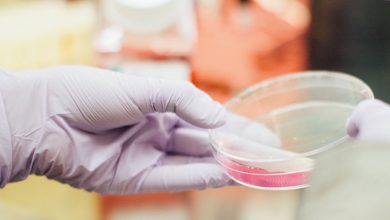

Gesundheit
- Dez.- 2018 -28 Dezember

Wenn der Storch nicht kommen will
Frauen bekommen die Kinder, aber zur Zeugung braucht es eben auch den Mann. Die Männer in den westlichen Industrienationen scheinen…
Weiter lesen » - 28 Dezember

Pflanzen für die Blase
Eine Blasenentzündung ist, das weiß jeder, der sie schon einmal gehabt hat, sehr unangenehm, man muss dauernd zur Toilette, es…
Weiter lesen » - Nov.- 2018 -30 November

Wurzelbehandelte Zähne
Ist ein Zahn ständig entzündet oder das darin befindliche Zahnmark bereits abgestorben, wird fast immer eine Wurzelkanalbehandlung durchgeführt. Dabei wird…
Weiter lesen » - 2 November

Fit und gesund im Alter mit besonderen Heilpflanzen
Es ist ja wirklich schön, dass wir u.a. durch die moderne Medizin und bessere Lebensbedingungen heutzutage deutlich älter werden können,…
Weiter lesen » - 2 November

Biologisches Dekodieren
Der Körper kann nicht lügen. Er drückt aus, was das aktuelle Problem darstellt. Oft stellt er sogar die biologische Lösung…
Weiter lesen » - Sep.- 2018 -28 September

Osteoporose lindern mit der Kraft der Natur
Unser Skelett ist kein starres Gerüst, im Gegenteil ist es ein festes und vitales Gewebe, das unablässig umgebaut wird. Die…
Weiter lesen » - 28 September

Wechseljahre
Hitzewallungen, Stimmungsschwankungen, Schwindel, Gewichtszunahme und Osteoporose sind klassische Beschwerden von Frauen in den Wechseljahren. Im Alter zwischen 45 und 55…
Weiter lesen » - 28 September

Schulden bei der Krankenkasse?
Rund acht Milliarden Euro schulden deutsche Versicherte ihren gesetzlichen Krankenversicherungen. Viele Schuldner sind hauptberuflich Selbstständige in einer finanziellen Schieflage: Nicht…
Weiter lesen » - Aug.- 2018 -30 August

Antibiotika
Antibiotika sind zweifelsohne eine segensreiche Entdeckung. Sie haben schon vielen Menschen das Leben gerettet und werden es auch weiter tun.…
Weiter lesen » - Juli- 2018 -27 Juli

Ess-Störungen
Jeder zweite Deutsche wäre gerne schlanker. Die Themen Ernährung und Figur werden immer mehr zum Problem in unserer Gesellschaft. Gerade…
Weiter lesen »